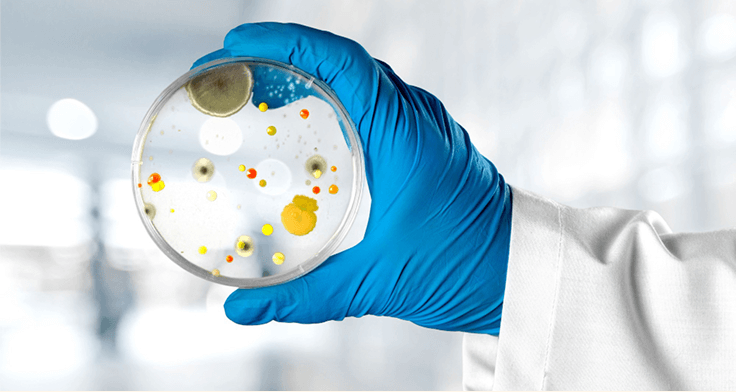

- Магазин , офис, склад - Северный проезд, 30/3
- Магазин Сухарная, 68
- Магазин Никитина, 162
- Магазин Кирова, 319
- Магазин Станционная, 59/2
- Магазин Станиславского, 32
- Магазин Мира, 19
- Магазин Демакова, 23/5
- Магазин Большевистская, 175/6
- Магазин Петухова, 35
 8-800-201-5400
8-800-201-5400
- Заказать звонок
- Написать в MAX
- Написать в Telegram
- Избранное 0
- Войти на сайт
- Стать партнером
- Главная
- Розничные магазины
- Покупателям
- О компании

- Розничные магазины
- Покупателям
- О компании
- Стать партнером
- Написать в MAX
- Написать в Telegram
Не буду менять фильтр салона
Между тем, отказываясь от замены салонного фильтра, вы рискуете своим здоровьем. Золотистый Стафилококк, Клебсиелла, кишечная палочка - эти болезнетворные бактерии и другие патогены (дрожжи, плесневые грибы) могут обитать на любых поверхностях, если для их роста созданы хорошие условия, такие как высокая влажность и питание.
Вместе с наружным воздухом на поверхность фильтрующего материала может попасть множество источников пищи, начиная от мелких насекомых, пыльцы и других частиц.
Разрастаясь, патогены выделяют токсины прямо в салон автомобиля и несут опасность для здоровья человека, особенно с ослабленным иммунитетом.
Своевременная замена салонного фильтра, создание враждебной среды для их развития (например, антифунгицидная и антибактериальная обработка) позволяет снизить риски для здоровья и повысить комфорт на протяжении пути.
А вы забываете менять фильтр в салоне?
© 2000-2026, ООО "Торговый Дом Волга Моторс"